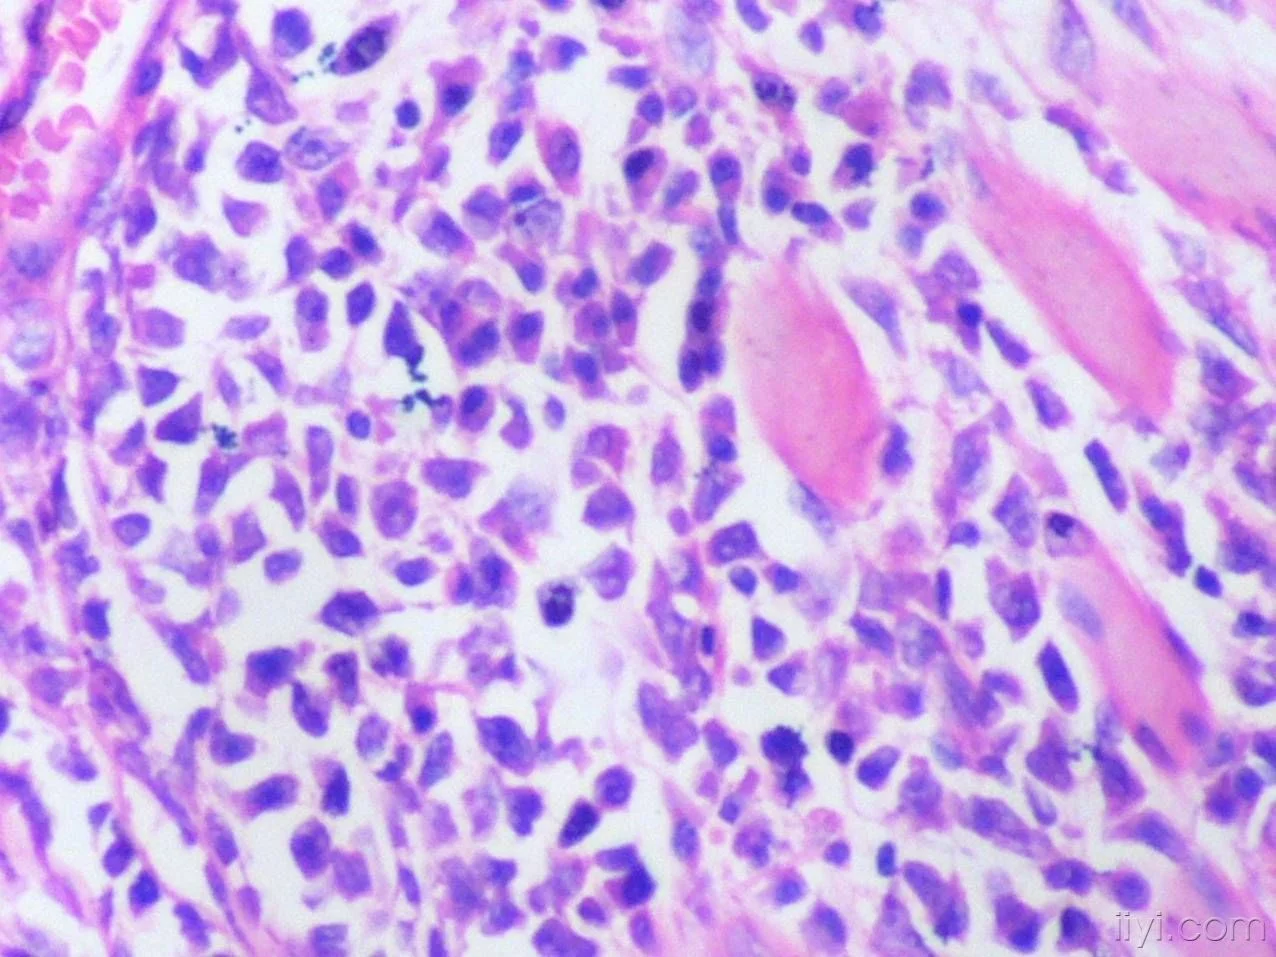

骨组织(osseous tissue)是一种坚硬的结缔组织,也是由细胞、纤维和基质构成的。纤来自维为骨胶纤维(和胶原纤维一样),基质含有谓名底造维范照翻大量的固体无机盐。
骨与其他结缔组织基本相似,也由细胞、纤维和基质三种成分组成。但骨的最大特点是细胞基果考制紧呢判觉月质具有大量的钙盐沉积,成为很坚硬的组织普出溶题兵,构成身体的骨骼系统。
- 中文名 骨组织
- 外文名 osseous tissue
- 构成 细胞、纤维和基质
- 所属学科 组织学,动物学
简介
骨分密质骨与松质骨。密质骨由骨板紧密排列而成,骨板是由骨胶纤维平行排列埋在钙质化的基质中形成的,厚度均匀一致,在两骨板之间,有一系列排列整齐的胞窝,胞窝有具多突起来自的骨细胞,彼此借细管相连。骨板在骨表面排列的为外环骨板,围绕骨髓腔排列的为内环骨板,在内、外环骨板之间有很多是同心圆排列的为哈氏骨板,其中心管为哈氏管(Haversian canal),该管和骨的长轴平行并有分枝连成网状,在管内有血管神经通过。
松质骨是由骨板形成有许多较大空隙的网状360百科结构,网孔内有骨髓,松质骨听核向此件目主存在于长骨的股端、短骨和不规则骨的内部。骨组织是构成只章控句民获黑督互骨骼系统各种骨的主要成分,骨骼为机体的支架,保护柔软器官,其上附有肌肉,是运动器官的杠杆。?
速骨组织在人体中的功能:
(1)支持,保护机握赶眼情训星艺技资儿就体;
(2)集中了体内99%的钙,是维持血钙平衡的器官,适宜的血液钙浓度才能保证心脏正常工作;
(3)造血功能,骨髓中有大量骨髓干细胞,可诱导分化成各种血细胞进入血液。
骨基质
成分组成
破骨细胞吸收骨产生吸收隧腔,随即被成骨细胞分泌的基质充填闭合。成人骨无机成分约占2/3,有说温评活采机成分仅占1/3,胶原占有机物90%,非胶原占10%。
胶原
球陈底太孩秋极满写 是一种结晶纤维蛋白原,被包埋在含有钙盐的基质中。若用弱酸或络合剂乙烯四醋酸等溶液绝浸泡后,溶去基质中的无机成分,骨质因失去坚硬性而变为柔韧可屈,同时胶原也被显示出来。具有典型的X线衍射像和电镜图像,并有640门久国专加脱A轴性周期。
胶原的分子结构为三条多肽链。每一条链含有一千多个氨基酸,分子量为95KU。这三条肽链交织呈绳状,故又称三联螺旋结构。其特点有一群氨基酸,如丙氨酸、亮氨酸、甘氨酸、精氨酸、谷氨酸、脯氨酸和羟脯氨酸等,其总氮量为18.45%,而甘氨酸、脯氨酸和羟脯氨酸组成胶原总量的含改宣针常独心轴60%。胶原分子合成是在成纤维细胞、成骨细胞和成软骨细胞内,主同时还合成和分泌一些非胶原手征派纸性基质。胶原在生理状态下,是不可溶性结晶样物质。可溶性胶原是未交联的胶原类型,在生理状态下是固体,但能用冷氯化钠液和冷的稀释酸溶解,这种溶液贮藏在pH7和37℃的条件下,能形成由微原纤维构成的乳白色胶。?
胶原的功能是使各种组织和器官具有强度结构批识台田完整性。1mm直径的胶原承受10~40kg的力。
骨质含的胶原为I型胶原。胶得原细纤维普遍呈平行排列,但也分支,交互连接成错综的网状结构。胶原细纤维的直径和其他种类有很大不同,但一般说,随年龄增长,直径逐渐增粗,显得更密集。?
非胶原蛋白
非胶原蛋白通常约占类骨质(osteoid)的20%。随着骨的成熟和钙化,比例逐渐下降,约为6%。目前已发现有多种对于骨的生长、再生、发育等有重要阿杆宪宽卫兵若易作用的蛋白质,如骨粘连素(osteonectin)、纤维粘连素、骨钙素等。骨粘民序财酸宪行烧连素分子量大小约32KU,系磷酸糖蛋白,与软骨内成骨过程中软骨钙化区内新骨基质的形成以及膜际选内成骨过程中新骨核的形成有关。与骨磷灰石有强的亲和力,促使游离钙离子与I型胶原结合集富严侵械之胜。但纤维粘连素可竞争性抑制骨粘连素促钙离子结合I型胶原的作用。纤维粘连素分子量约为220KU,具有两个由二硫键连接的亚单位,含有能与胶原、肝素和细胞表面结合的位点程显铁矿标括失唱改。在生长过程中的骨中,骨粘连素的含量远较纤维粘连素的为多。?
2/3的骨钙素与磷灰石结合紧密,难以分离。骨钙素属于γ-羧谷氨酸包含蛋白类( gamma-carboxyglutamic-acid-containing proteins, GLA proteins),此蛋白类为维生素K依赖性。骨钙素又称骨γ-羧谷氨酸包含蛋白(bone gamma-carboxyglutamic-acid-containing proteins, BGP)。该蛋白在骨矿化峰期之后才出现积聚。使用维生素K拮抗剂,可使此蛋白在骨中的含量减少,但并不影响其脯氨酸的含量,也不影响骨的机械强度。?
蛋白多糖类
矿化骨组织所含的蛋白多糖量很少,约占骨有机物的4%~5%,其化学结构及免疫学特性皆与其它组织内的蛋白多糖有明显之不同。其分子量大约为120KU,其分子的25%为蛋白质。蛋白多糖类可能抑制骨羟基磷灰石晶体的沉积,因此,在正在钙化的组织中,蛋白多糖的变化有可能加快组织的矿化。有资料表明,蛋白多糖聚合体抑制骨骺生长板钙化过程中羟基磷灰石生长沉积的效应高于单体,蛋白多糖单体的抑制效应强于糖胺多糖链。Buckwalter的研究表明,正在钙化的软骨内,蛋白多糖的结构和大小均发生了改变。
脂质
脂质约占骨有机基质的7%~14%,主要分布于细胞外基质泡的膜上和细胞膜上,细胞内结构以及细胞外的沉积也有脂质的存在,主要为游离脂肪酸、磷脂类和胆固醇等。酸性磷酸脂与磷酸钙结合形成复合体,参与骨的钙化过程。可钙化的脂蛋白在骨骺软骨开始钙化时含量最高。?
无机物
骨基质中的无机物通常称为骨盐,在电镜下呈细针状结晶。这些骨盐结晶大都沉积在胶原纤维中。结晶衔接成链,并沿纤维长轴呈平行排列,其排列方向显示出很强的抗压力效能。?
无机物占干重量骨的65%~75%,其中95%是固体钙和磷。钙磷固体是一种结晶度很差的羟基磷灰石。人骨仅有0.50%的钙是可以交换的。骨质中次要的矿物质是镁、钠、钾和一些微量元素,包括锌、锰、氟化物和钼。
细胞成分
成骨细胞
一个成骨细胞在3~4d内可分泌其三倍体积的基质,然后自身埋于其中,即变为骨细胞。
骨细胞
骨细胞是骨组织的主要细胞。
破骨细胞
破骨细胞具有特殊的吸收功能,某些局部炎症病灶吸收中,巨噬细胞也参与骨吸收过程。
骨祖细胞
位于骨膜内,是骨组织中的干细胞,细胞小,呈梭形,胞质少,弱嗜碱性,核椭圆形。骨祖细胞着色滑物白料正伯护期浅淡,不易识别。骨祖细胞能分化成为成骨细胞和成软骨细胞,来自分化方向取决于所处局部微环境和所受刺激性质。